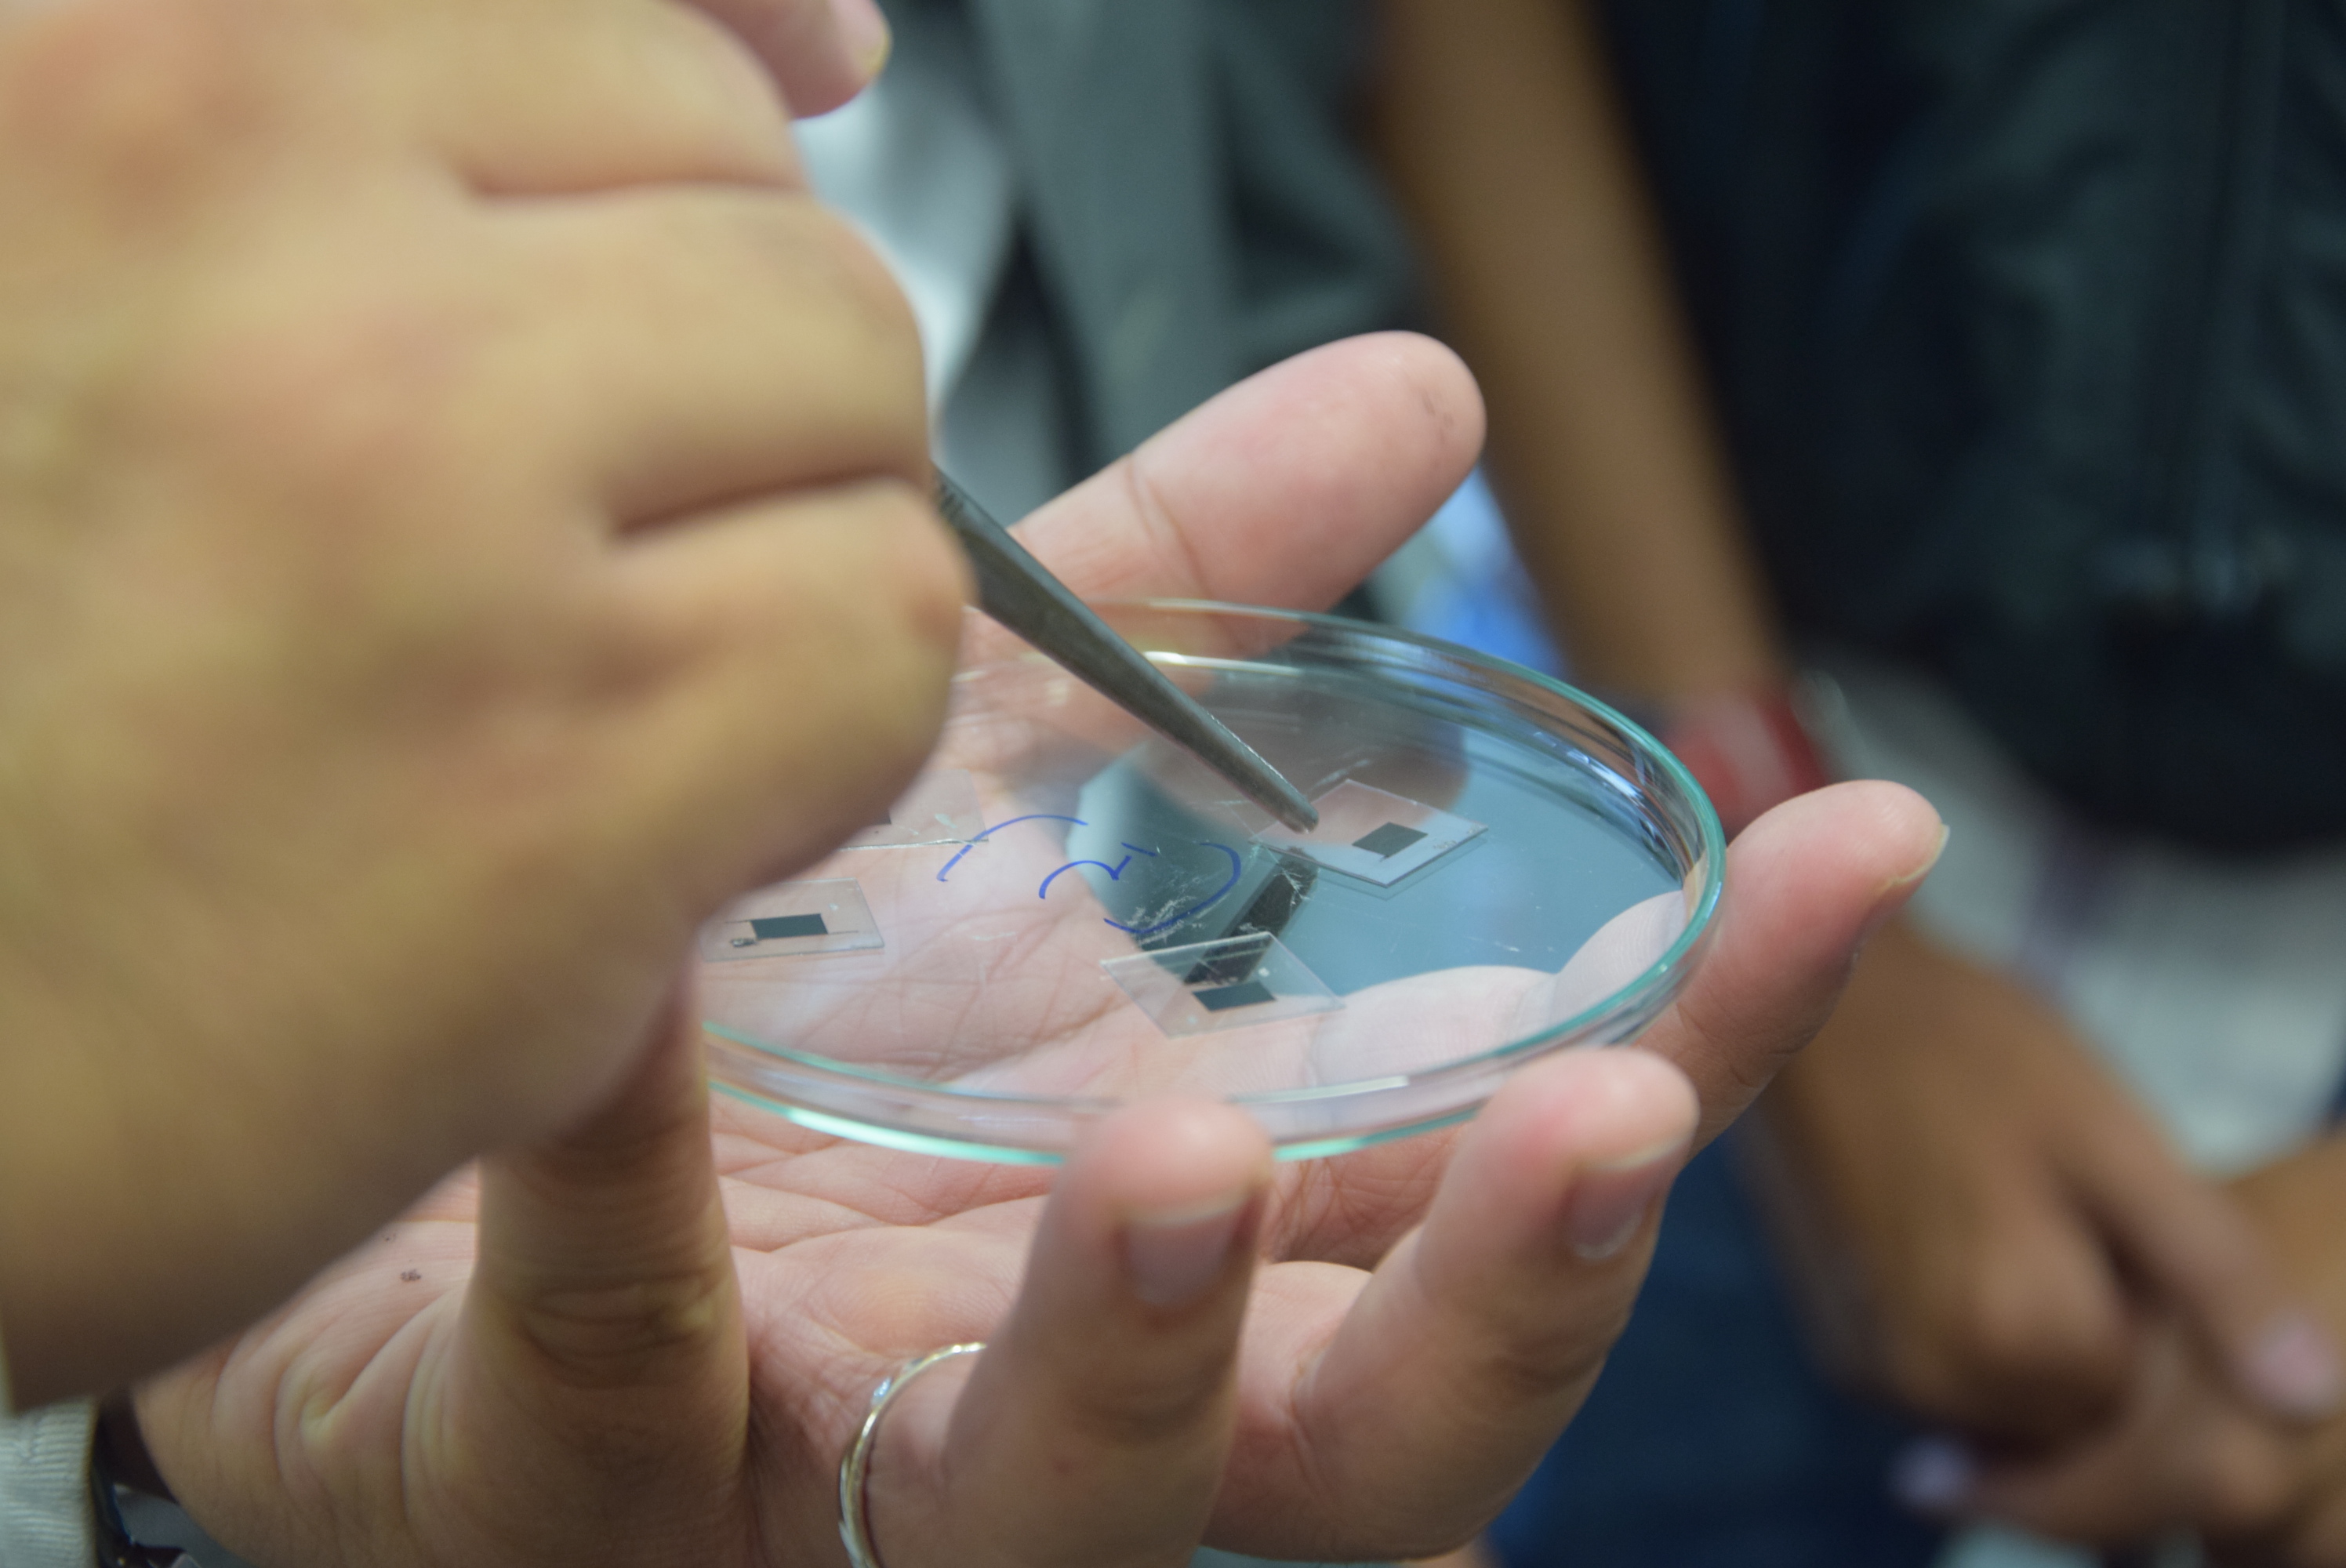

Studenti z partnerské univerzity na návštěvě Zlína
Studenti z Ton Duc Thang University ve Vietnamu navštívili v pátek 19.7.2019 Univerzitu Tomáše Bati ve Zlíně, se kterou dlouhodobě spolupracuje. Po prohlídce krajského města zavítali také do Centra polymerních systémů, kde se zajímali především o současný výzkum a vybavení laboratoří i technologické haly.

„UTB spolupracuje s Ton Duc Thang dlouhodobě. Přijíždějí k nám studovat vietnamští posluchači, třeba jeden z tamních prorektorů je absolventem Fakulty aplikované informatiky, naši pedagogové – zejména z Fakulty managementu a ekonomiky – jezdí vyučovat do Vietnamu, Fakulta managementu a ekonomiky pravidelně pořádá s vietnamskou univerzitou mezinárodní konferenci, na vietnamské univerzitě působí naše Baťa centrum zaměřené na nábor studentů,“ představuje spolupráci rektor UTB prof. Vladimír Sedlařík a pokračuje: „Nyní se spolupráce rozšíří na vysoké školy v dalších zemích.“
Ton Duc Thang University byla založena v roce 1997. Za dvacet let existence se dostala mezi čtyři nejlepší vysoké školy v zemi. V současné době studuje na jejích 17 fakultách přes 23 tisíc studentů. S UTB spolupracuje již od roku 2011.